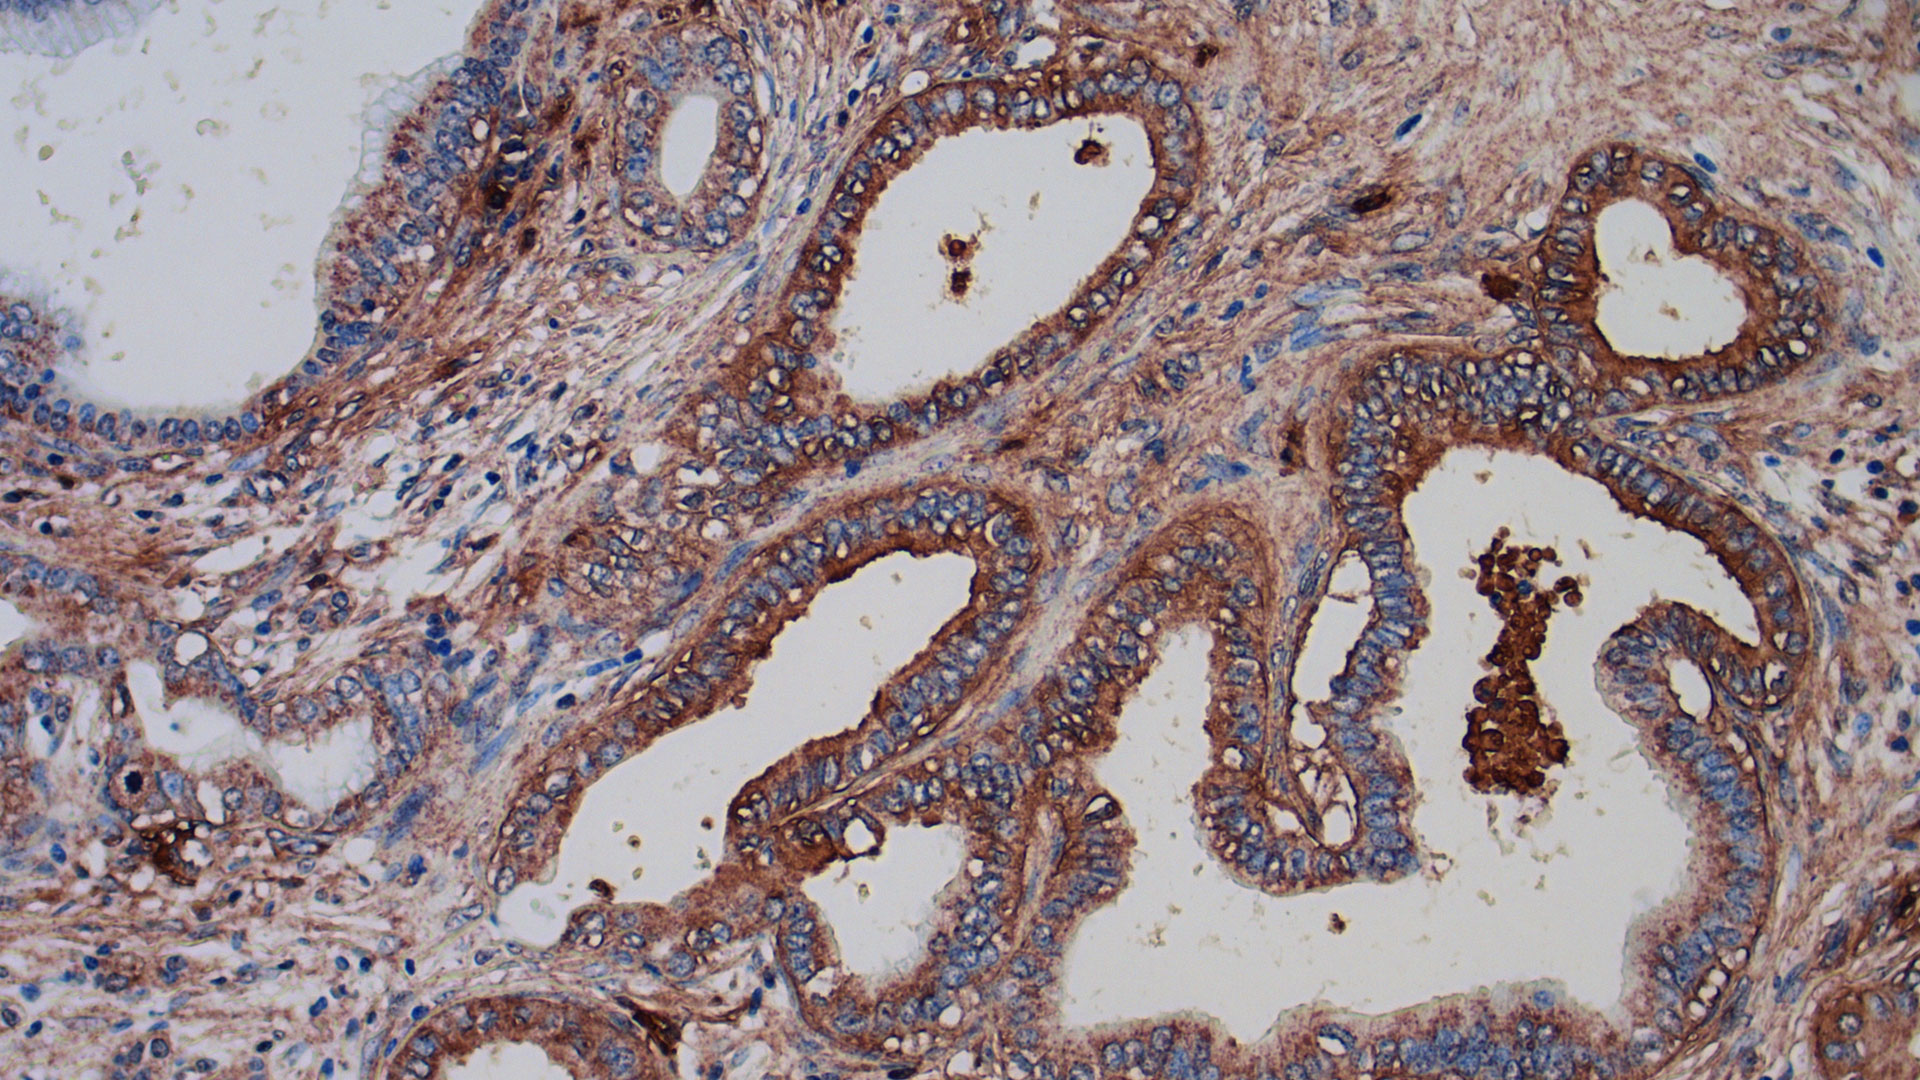

プレスルーム
日本支社長メッセージ
Message from Japan Country Managing Director
2024年度、新しい年度が始まりました。
2023年にSRI日本オフィスは創立60周年を迎え、60年にわたり日本のお客様やパートナーの皆様に対して、揺るぎない献身を続けてまいりました。60周年の節目に東京オフィスは東麻布に移転し、皆様とのより一層深い絆を大切にする象徴としてリニューアルしました。そして、私たちはSRIの受託研究開発を通じて、AI、ロボティクス、バイオサイエンス、材料科学など最先端技術を提供し、熱意を持って日本の多様な産業をサポートさせていただきました。
また、昨年はPARC(パロアルト研究所)がSRIの組織に統合されたことで、SRIの能力は拡大し、日本のお客様にさらに幅広いサービスを提供できるようになりました。2024年度の新年度が始まり、SRIは日本におけるイノベーションの促進、およびSRIの研究開発受託やイノベーションプログラムを通じて日本のイノベーターの皆様の支援に引き続き尽力しながら、世界トップクラスのサービスをさらに拡充していく所存です。
本年度もSRIをよろしくお願い申し上げます。
SRIの最新情報については、下記リンクをクリックしてください:

SRI日本支社長
イギデル ユセフ
SRIの最新情報やブログのご紹介
-

日本のイノベーションを牽引する
人々や言語、文化に対する思いを活かして人間関係を築き、変化を促す
-

SRIは革新的な追跡技術でスペースデブリの危険性に取り組む
何十万個という小さなスペースデブリが地球軌道上で未だに追跡されておらず、人類の宇宙開拓を危険にさらしている
-

SRIがAIを活用した創薬プラットフォーム「Synfini」をスピンオフ
Synfiniは医薬品製造を加速するため、自動化合物試験を商業化し拡張
-

インクから生まれる「chiplets(チップレット)」で、ディスプレイや電子機器を直接プリントする未来
研究者たちは、チップレットを含んだ新しいインクを活用し、統合されたシステム上にプリントする先進的な製造方式でコ…
-
がんと闘うための新しいプレシジョン免疫療法に取り組むSRI
標的抗原負荷リポソームのプラットフォームは、効果的かつ個別化したがん治療の新時代をもたらす可能性を秘めている
-

画像データの保存と共有を容易にするSRIの技術
より優れた圧縮とデータ保存を実現するため、詳細な航空地図と3Dデータを組み合わせてセンシング技術とイメージング…
-

新しい拡張現実システムは、よりスムーズで没入感のある体験を提供
地上と上空からの映像をコンピューターの生成要素と組み合わせることで、地上のユーザーはより正確な拡張現実の映像を…
-

マーケティング用のマルチモーダルAIを設計
GoCharlie.aiの創業者兼CEOは、SRIと協力してデジタルコンテンツの制作現場へ改革をする
-

SRI主導のチームが生体磁気信号を検出する磁気センサーを実証
AMBIIENTは、いくつかの病状を診断できる信号を分析する
-

アパラチア地域の教育改善にSRI Educationの研究を活用
SRIが運営する「REL Appalachia」は、学校や学区と提携して家庭や教師が生徒を支援するために必要な…
-

SRI、変革を表現する新しいブランドアイデンティティを発表
革新的な新ブランドは、75年以上にわたって世界を変えてきた、そしてこれからも変え続ける技術、サービス、アイデア…
-

SRIの研究者、膵臓がんを標的として治療するバイオマーカーを特定
膵臓がんを標的とする分子を、SRIのFOX Three分子誘導システムを活用して開発
-

SRIの科学者がグライコミクスのプロトコルを科学界に公開
微生物やがんの糖鎖シグネチャーを探索する戦略を語る
-

思春期の睡眠と健康全般の深い結びつきを探る
青少年期の脳の発達には良質な睡眠パターンが重要
-

イノベーションで一歩先へ:激動の時代に成功を維持する
イノベーション戦略の策定が「不確実な時代を乗り切る鍵」となる
-

昆虫は「におい」を介してどのようにコミュニケーションをとっているのか
昆虫の「化学的な物質」を介したコミュニケーションを理解すれば、作物の保護や刺咬で感染症を媒介する昆虫から人類を…
-

SRIが開発した新しい溶接ヘルメットの技術は、溶接作業中に鮮明で高精細な3Dビューをリアルタイムで提供
SRIはこの技術のライセンスを川田テクノロジーズ株式会社に供与、このヘルメットを世界中に向けて商用化へ
-

SRIの放射能汚染治療薬、初のヒト臨床試験へ
多才な科学者のチームによるこの研究は、HOPO 14-1の安全性を確立するために不可欠なデータを提供する
メディアからのお問い合わせ
Kaleigh DeBias
Communications Manager, Corporate Marketing & Communications
Kunika Kumagai
Marketing Specialist
SRIブランド資産
SRIには、複数のタイプのロゴがあります。適切な使用方法については、弊社にご連絡の上、下記リンクより 「Visual identity brand guidelines」 を参照してください。